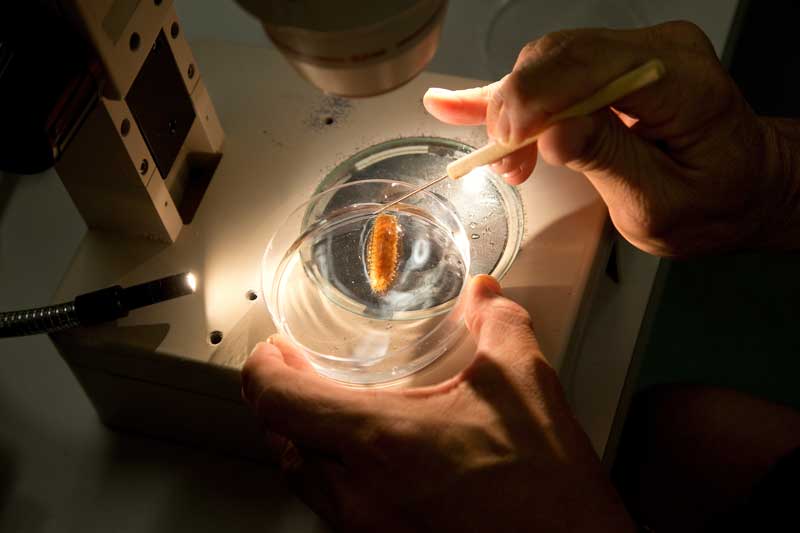
biology lab

Biology field lab (SUNY Geneseo photo/Keith Walters ’11)
In a four-year study, a group of science faculty finds that student buy-in to a new curriculum, and therefore satisfaction, increases with each successive undergraduate cohort — and learning gains did not suffer. The researchers say the results of their longitudinal study should help encourage college faculty and administration to create, adapt, and support innovative courses for their students.
Over the past few decades, biologists have learned that the most effective ways of teaching biology are to move away from lecture-based classes and to be more inclusive to students across majors, with student-centered curricula and hands-on discovery as a critical component to learning.
“It takes a long time for programs and institutions to adopt changes,” said Suann Yang, an assistant professor of biology at SUNY Geneseo. “But because of the strong evidence for better methods in teaching biology, we decided to incorporate them into an innovative curriculum where students are grappling with bigger, complex issues, and try to solve problems using ideas throughout biology in an integrative fashion. To better understand curricular transformations more fully, we also decided to administer assessments for student attitudinal changes in addition to the usual learning gains.”
The full study appears in PLOS ONE.
Yang, along with four colleagues, who, at the time, taught at the same small liberal arts college, devised a new introductory course, Integrating Biology with Inquiry Skills (IBIS), that teaches the standard biology curriculum in nine overarching modules, or scenarios. The course was taught to 724 students by 13 faculty members over four years.
“As students work through each scenario, they are integrating their knowledge as they go,” said Tarren Shaw, Ph.D., co-author and lecturer of biology at the University of Oklahoma. “One example is that students will study the immune system, the ecology of population growth, and coevolution in a module about disease. This format takes students from the cellular level to beyond the species level, while studying short- and long-term processes, in one scenario.”
Together with the scenario framework, the IBIS coursework has students investigating particular questions they design in the lab that are related to the scenario.
“This is very different from conventional, lecture-based classes that are accompanied by cookbook labs, a protocol-12 that all students follow to arrive at the same result,” added Shaw. “The IBIS curriculum is not just about learning the biological concepts but how to study it, how to be curious about it, ask questions, and use your knowledge to discover more.”
Jeffrey Grim, an assistant professor at the University of Tampa, noted that multiple assessments were needed to measure student learning. “Besides pretests and posttests, we also did fairly extensive attitudinal surveys and other surveys to try to understand how or if students associate any learning they acquired with the curriculum they’ve experienced. We had success all around — we had good learning gains, and we also found that over time, students recognized that how they were taught was linked to their understanding of how much they learned,” Grim said. “Students were able to increasingly attribute specific components of the new student-centered course to their learning.
“The second part of the story is that change takes time and it’s hard,” said Grim. “Experts in institutional change theory have established this, but experiencing it firsthand was useful to us, because as individual faculty members who are trying to make changes in the way we teach, it’s often very frustrating when students are upset because ‘this isn’t how my older brother or people in my sorority did it.’ Of course, it may not be any harder; it’s just different.”
The researchers report that all of the analysis shows that there was some resistance at the beginning when students first faced the curriculum change. But after four years, when it became the norm throughout the student body, it was fully adopted by the students.
“We worked hard every year to make the course better. We’d take the course evaluations and address any issues students identified,” said Yang. “When we’re in the thick of it we tended to focus on what we needed to improve rather than the bigger patterns. But when we were able to look back and see these larger longitudinal trends, we saw that most of our students say the course was really good for them — that they learned a lot and know why they learned it — we were super excited!”
The researchers point out that faculty who want to make changes should not hesitate, but everyone in the program should recognize that it will take time. “If everyone shares a goal, then it is important to support each other and stick with it,” said Yang.
The researchers are making the IBIS curriculum available as an open educational resource (OER) with support from SUNY Geneseo’s Milne Library’s Open Services Team. As well as being free to access and download, the curriculum materials are openly licensed so other faculty and schools can adopt and make adaptations. Currently, two modules have been released, with more to be published this year. Each module is centered on a framing scenario that serves to engage students and provide a context for them to explore the intended learning outcomes with an emphasis on collaborative investigation.
Author
Monique Patenaude, PhD
Executive Director of Content Strategy & Media Relations
(585) 245-5056
Related Stories
No post found!
